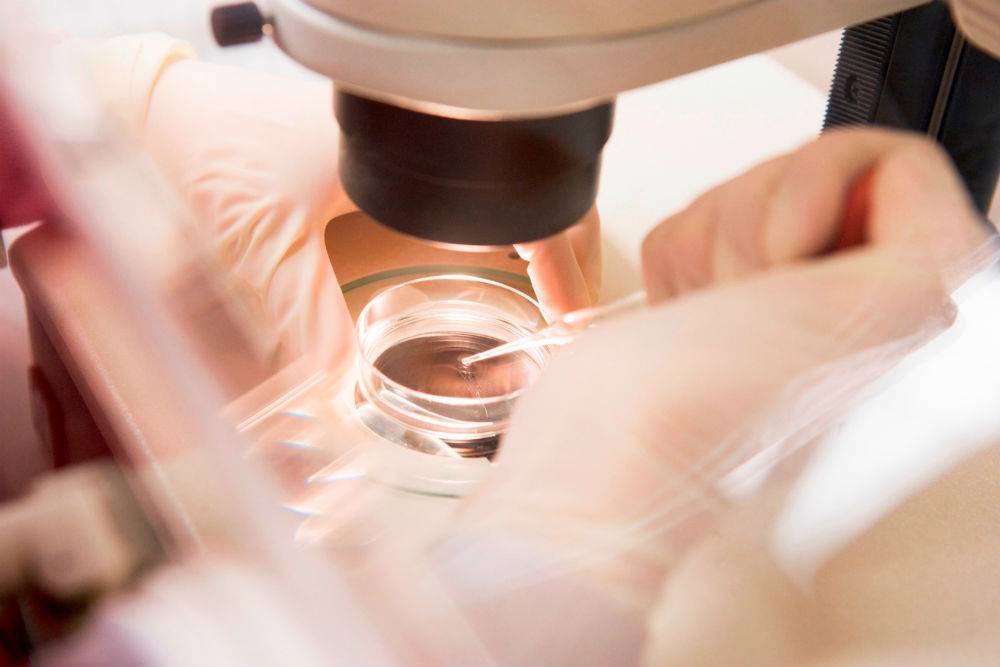

SQLITE NOT INSTALLED
Как принять решение при бесплодии
Если пара не может завести детей не более 2 лет, внутриматочная инсеминация не показана, так как шансы забеременеть при ней не выше, чем при обычной половой жизни. Если же история бесплодия более 3 лет, инсеминация становится эффективным инструментом. Таковы данные статистичесих исследований.Несмотря на более высокую эффективность процедуры ЭКО, внутриматочная инсеминация является востребованной, в первую очередь благодаря низкой стоимости по сравнению с другими методами вспомогательных репродуктивных технологий.
в акушерстве и гинекологи мы работаем по таким направлениям как:
- Ведение беременности с ранних сроков до родов
- Женская консультация
- TORCH инфекции (торч-инфекции)
- Антифосфолипидный синдром
- Базальная температура
- Беременность
- Ветрянка при беременности
- Планирование беременности
- Лекарства при беременности
- Внематочная беременность
- Восстановление промежности после родов
- Выделения у женщин из влагалища, выделения при беременности
- Выкидыш (самопроизвольный аборт)
- Рецидивирующее невынашивание беременности
- Генитальный герпес во время беременности
- Задержка месячных
- Замершая беременность
- Инфекции мочевыводящих путей у беременных
- Интимная пластика без операции
- Календарь беременности
- Лактация
- Многоводие у беременных
- Овуляция
- Определение пола ребенка
- Отеки при беременности
- Первые признаки беременности: симптомы беременности
- Прерывание беременности
- Пренатальный скрининг (двойной и тройной тест)
- Резус конфликт при беременности
- Тест на беременность
- Токсикоз при беременности
- Узи-диагностика синдрома Дауна и других хромосомных аномалий
Лечим такие проблемы:
- Аденомиоз
- Андексит
- Бактериальный вагиноз
- Бели
- Боли внизу живота
- Боль при мочеиспускании
- Боли при месячных: если в месячные болит
- Бесплодие
- Бесплодие при метаболическом синдроме: бесплодие у женщин с избыточной массой тела
- Необъясненное бесплодие
- Вагинальное кровотечение
- Вагинит
- Вирус папилломы человека (ВПЧ)
- Восстановление проходимости маточных труб
- Воспаление придатков
- Воспаление шейки матки
- Генитальный герпес
- Гиперплазия эндометрия
- Гарднереллез
- Дисплазия шейки матки
- ИППП
- О схемах лечения ЗППП
- Зуд половых органов
- Кондиломы
- Киста яичника
- Климакс
- Кровь в моче (гематурия)
- Кольпит
- Мастопатия
- Маточное кровотечение
- Месячные (менструация)
- Миома матки
- Микоплазмоз
- Молочница
- Папилломавирус
- Поликистоз яичников
- Полипы
- Противозачаточные средства
- ПМС — предменструальный синдром
- Рак матки
- Рак шейки матки
- Ранний климакс (ранняя менопауза)
- Синдром поликистозных яичников
- Спираль (внутриматочная спираль)
- Трихомониаз
- Уреаплазмоз
- Хламидиоз
- Цервицит
- Цистит
- Частое мочеиспускание
- Эрозия шейки матки
- Эндометрит
- Эндометриоз
- Эндоцервицит
Оперативная гинекология:
- Диагностическая гистероскопия (офисная)
- Хирургическая гистерорезектоскопия
- Диагностическая лапароскопия
- Лапароскопическая пластика маточных труб
- Лапароскопическая миомэктомия
- Лапароскопическое лечение внематочной беременност
- Лапароскопическое лечение эндометриоза
- Лапароскопическое лечение пролапса органов малого таза
- Лапароскопическое удаление кисты яичника
- Лапароскопическое лечение поликистоза яичников (дриллинг)
- Пластика малых половых губ
- Пластика влагалища после родов
- Хирургическое лечение недержания мочи
- Хирургическое лечение бартолинита (киста, абсцесс бартолиниевой железы)
Цены на услуги
| Первичная консультация врача гинеколога-репродуктолога | 2500р |
| Внутриматочная инсеминация (ВМИ) | 21000р |
| Созревание яйцеклеток in vitro (IVM) | 29000р |
| Вспомогательный хэтчинг эмбриона | 8000р |
| Перенос замороженных эмбрионов | 30000р |
| Внутрицитоплазматическая инъекция сперматозоида (ИКСИ) | 40000р |
| Селекция зрелых сперматозоидов ИМСИ | 10000р |
Широко известная как искусственная внутриматочная инсеминация (ВМИ) традиционно считается промежуточной ступенью в лечении бесплодия до появления первых попыток ЭКО.
Искусственная инсеминация — метод лечения бесплодия, заключающийся во введении специально обработанного эякулята во влагалище женщины вне полового акта. Инсеминация используется при следующих проблемах у мужчин: при импотенции, отсутствии эякуляции или низком содержании сперматозоидов в эякуляте; при следующих проблемах у женщин: при цервикальном бесплодии (изменение свойств слизи матки, препятствующее проникновению необходимого количества сперматозоидов в матку) или при вагинизме (непроизвольные сокращения мышц влагалища, зачастую вызванные боязнью полового акта) у женщин. При полной непроходимости маточных труб у женщины инсеминацию не делают, а приступают сразу к ЭКО. Продолжительность процедуры искусственной инсеминации составляет всего несколько минут. Зачастую инсеминацию проводят в середине менструального цикла, во время овуляции, спермой, прошедшей специальную обработку. Во время обработки сперму делают более концентрированной и освобождают её от патологических сперматозоидов. Это обусловливает большой процент успешных оплодотворений.
Также существует вид инсеминации спермой донора при полном отсутствии сперматозоидов мужа или при генетических отклонениях у мужчины.
Большинство женщин характеризуют эту процедуру как безболезненную, напоминающую взятие мазка со слизистой шейки матки, хотя после возможны небольшие спазмы, дискомфорт.
Процент успеха внутриматочной инсеминации составляет 18-30 % для одного цикла.
Последние исследования обнаружили, что внутриматочной инсеминации и естественный половый акт имеют похожие показатели успеха, что в целом умаляет полезность ВМИ как стандартной технологии вспомогательного оплодотворения. По этой причине клиника Аймед, после двух- трех неудачных попыток инсеминации сразу переходит к лечению методом ЭКО, экономя тем самым ваше время и средства.
Как подготовиться к ЭКО мужчине?
Ошибочно считать, что подготовка перед экстракорпоральным оплодотворением – исключительно женская прерогатива. Мужчина также принимает участие в этом процессе и должен в течение 3 месяцев до процедуры выполнять следующие рекомендации:
- Перегрев тела выше температуры в 38 градусов Цельсия негативно влияет на качество спермы. Поэтому в данный период мужчине необходимо воздерживаться от посещения саун, бань, приема горячей ванны.
- В течение 3 месяцев до ЭКО необходимо отказаться от употребления алкоголя, сигарет и психоактивных веществ. Прием лекарственных препаратов нужно сократить до жизненно необходимых, согласовав при этом стратегию терапии с лечащим врачом.
- Ограничить или полностью исключить высокие физические нагрузки, особенно связанные с поднятием тяжестей. Рекомендуется также заменить бег на продолжительные прогулки.
- Избегать ношения тесного нижнего белья, которое повышает температуру в области промежности и вызывает застойные явления в семенных железах и протоках.
Также обоим партнерам рекомендуется пройти тесты на выявление заболеваний половых органов
В частности, при появлении признаков генитальной герпесной инфекции необходимо сообщить о них врачу, так как эта патология является важной причиной прерывания и переноса процедуры ЭКО до момента ее излечения.
Этап 2 — Гормональная терапия
Следующий этап процедуры ЭКО начиняется на второй день менструального цикла и длится от 12 до 14 дней. Суть его состоит в том, чтобы при помощи гормональной терапии простимулировать работу яичников для получения 8–10 ооцитов, способных к оплодотворению. Именно такого количества будет достаточно для успешного проведения ЭКО.
Во время проведения гормональной терапии каждые четыре дня в обязательном порядке проводится УЗИ органов малого таза, в соответствии с результатами которого доктор может скорректировать дозировку препаратов.
Для проведения процедуры классического ЭКО может использоваться фолликулостимулирующий гормон гипофиза ФСГ, ионический гонадотропин и аналоги гонадолиберина. Врач назначает схему лечения в зависимости от протокола, который будет выбран для проведения ЭКО.
Международным научным сообществом одобрены разные протоколы стимуляции овуляции:
- Супердлинный — он длится 2–3 месяца;
- Ультракороткий — длится до 10 дней и предполагает высокие дозировки гормонов Обычно этот протокол назначается при таких диагнозах, как недостаточный фолликулярный резерв и низкий уровень гормона АМГ;
- Протокол ЭКО в естественном цикле — в этом случае не проводится гормональная стимуляция, и для оплодотворения берется одна яйцеклетка, которая созрела в естественном менструальном цикле;
- Протокол ЭКО с минимальной стимуляцией — для стимуляции используются небольшие дозы гормональных препаратов.
Чаще всего применяется короткий протокол, поскольку у женщины, нуждающиеся в экстракорпоральном оплодотворении, имеются серьезные проблемы с яичниками. В любом случае врач выберет для ЭКО наиболее безопасный для здоровья протокол. Очень часто вначале используют протокол ЭКО в естественном цикле, чтобы избежать гормональной нагрузки на организм, и только если этот метод не принесет результатов, назначается гормональная стимуляция.
Преимущества
Проведение внутриматочной инсеминации имеет ряд преимуществ в сравнении с другими методиками:
- Цена. Стоимость процедуры доступная. Это одна из самых недорогих методик лечения бесплодия.
- Отсутствие неприятных последствий. Манипуляция безболезненна. После процедуры не возникает гиперстимуляции и прочих проблем со здоровьем.
- Простота. Инсеминация не требует длительной специальной подготовки. Длительность процедуры не превышает получаса.
- Эффективность. Согласно исследованиям, которые были проведены Комитетом Великобритании по оплодотворению и эмбриологии человека (HFEA), более 50% женщин, прошедшим процедуру искусственной инсеминации, удалось забеременеть в одном из первых 6 циклов.
Для повышения результативности и достижения положительного результата от манипуляции внутриматочную инсеминацию рекомендуется проводить 2-3 раза во время овуляции.
Алгоритм программы искусственной инсеминации
Что представляет из себя программа искусственной инсеминации? После проведённого обследования супружеской пары и оценки проходимости маточных труб пациентка обращается в клинику в 3-7 день менструального цикла. В этот прием обсуждается программа проведения процедуры, проводится УЗИ органов малого таза, определяется дата последующего посещения. Как правило, при проведении программы необходимо несколько посещений гинеколога-репродуктолога:
- для ультразвуковой оценки роста доминантного фолликула и эндометрия;
- для введения спермы в периовуляторный период;
- для проведения УЗИ органов малого таза с целью установления факта беременности не ранее чем через 21 день после введения спермы в матку.
Если у пациентки не происходит собственной овуляции, проводится стимуляция работы яичников. При достижении доминантным фолликулом (или несколькими фолликулами) преовуляторного размера обычно назначают препарат, который вызывает овуляцию.
Если у пациентки не происходит собственной овуляции, проводится стимуляция работы яичников. При достижении доминантным фолликулом (или несколькими фолликулами) преовуляторного размера обычно назначают препарат, который вызывает овуляцию. Также по УЗИ оценивается рост эндометрия (внутренний слой матки), при его недостаточной толщине назначаются препараты для стимуляции роста.
За 1 программу можно провести двукратное введение спермы мужа с целью повышения вероятности зачатия. Первое введение – при достижении доминантного фолликула/ов преовуляторного размера, второе введение — с интервалом 1-2 дня, обязательно контролируется факт произошедшей овуляции с помощью УЗИ органов малого таза.
Подготовка спермы к введению (обработка свежей спермы) занимает около 1,5 часов.
Сама процедура введения спермы осуществляется на гинекологическом кресле (как на стандартном приеме у гинеколога). С помощью тонкого гибкого катетера сперма вводится непосредственно в полость матки. Процедура абсолютно безболезненна, некоторые пациентки могут испытывать едва ощутимое потягивание внизу живота. Вставать с кресла можно уже через 15-20 минут. В этот момент из влагалища может вытечь немного жидкости. Небольшое напряжение матки после ИИ – нормальное явление, оно проходит через несколько часов. Физические нагрузки на день процедуры необходимо свести к минимуму.
После процедуры искусственной инсеминации обычно назначаются препараты Прогестерона для поддержания оптимального гормонального фона, чтобы наступила беременность. Эти препараты принимаются до результата анализа крови на ХГЧ (назначается через 12- 14 дней после последнего введения спермы).
Если результат отрицательный, все назначенные в программе препараты отменяются и начинается менструация. Если результат анализа ХГЧ положительный, прием препаратов продолжается. УЗИ органов малого таза проводится не ранее чем через 21 день с момента последнего введения спермы для того, чтобы подтвердить наступление маточной беременности.
Эффективность искусственной инсеминации
По разным данным колеблется от 14 до до 20% на одну попытку. Существуют основные прогностические факторы, влияющие на эффективность инсеминации: возраст женщины, длительность бесплодия, качество спермы, количество предшествовавших попыток инсеминации. При различных причинах бесплодия инсеминация имеет разные шансы на успех. При неэффективности нескольких попыток ИИ рекомендуется приступить к лечению бесплодия методом ЭКО.
Подготовка
Если используется сперма партнера, материал может быть как свежеполученным, так и криоконсервированным. При инсеминации донорской спермой применяется только криоконсервированный эякулят и исключительно после подтверждения отсутствия у донора парентеральных инфекций (ВИЧ, сифилис, гепатит типа В и С).
Подготовка к ВМИ включает:
- сдачу анализа крови на ВИЧ, вирусные гепатиты В и С, TORCH, сифилис;
- спермограмму;
- MAR-тест;
- обследование обоих партнеров на наличие возможных инфекций, воспалений.
Если в ходе диагностики были обнаружены какие-либо заболевания, назначается их лечение, после чего анализы сдают повторно.
Максимальная вероятность оплодотворения приходится на период овуляции, поэтому инсеминацию проводят за день до нее или на следующий день после выхода яйцеклетки. Определить момент овуляции помогает фолликулометрия.
Обследования перед ЭКО
Перед проведением экстракорпорального оплодотворения обоим родителям назначается комплекс диагностических процедур, целью которых является:
- Определение причины бесплодия у одного или обоих родителей;
- Выявление возможных заболеваний, способных негативно сказаться на эффективности ЭКО или нанести ущерб матери и ее будущему ребенку;
- Оценка вероятности наступления беременности естественным образом и при экстракорпоральном оплодотворении;
- Оценка совместимости генетического материала обоих родителей для исключения резус-конфликта;
- Выбор наиболее эффективного протокола ЭКО, дополнительных репродуктивных технологий для повышения шанса наступления беременности.
Стандартный комплекс диагностики для женщин перед ЭКО включает следующие процедуры:
Анализы крови – клинический, биохимический (на белок, холестерин, мочевину, креатинин и т. д.), гормональный (АМГ, ФСГ, ЛГ и другие), на инфекции (ВИЧ, гепатиты В и С, сифилис, TORCH-комплекс), на резус-фактор и группу крови;
Мазки из цервикального канала и влагалища – микроскопическое исследование, посев на мико- и уреплазму, цитологическое исследование соскоба с шейки матки, исследование на ДНК хламидии, цитомегаловируса, герпесвируса;
Функциональные обследования – флюорография, электрокардиограмма, ультразвуковое исследование щитовидной и паращитовидной желез, органов малого таза, груди, маммография (для женщин старше 35 лет).
Будущий отец также должен пройти стандартный цикл диагностических обследований, включающий:
- Анализы крови – на группу крови и резус-фактор, госпитальный комплекс инфекций (ВИЧ, сифилис, гепатиты В и С);
- Спермограмму – исследование спермы на выявление количества и качества сперматозоидов, их морфологического строения, подвижности и т. д.;
- MAP-тест – исследование спермы на содержание антиспермальных антител, являющихся признаком аутоиммунного бесплодия у мужчин;
- Мазки из уретрального канала – на определение ДНК хламидии, цитомегаловируса, герпесвирусов, для микроскопического исследования отделяемого уретры, посев на мико- и уреплазму.
По результатам обследований врач (гинеколог или андролог) составляет заключение, в котором определяет причину бесплодия, наличие возможных заболеваний у родителей, шанс на успешное наступление беременности. При необходимости он может назначить прохождение дополнительных диагностических процедур для уточнения диагноза.
Показания к искусственной инсеминации
Данная процедура назначается в тех случаях, когда само зачатие естественным путем возможно, однако сперматозоиды не могут самостоятельно достичь полости матки — в частности:
- При незначительном снижении качества спермы — малоподвижные сперматозоиды, попадая во влагалище, погибают, не достигая полости матки;
- При различных сексуальных расстройствах у одного или обоих супругов, делающих невозможным полноценный половой акт — вагинизме, непроизвольных сокращениях влагалища у женщин, эректильной дисфункции у мужчин;
- При аномалиях женской репродуктивной системы — например, при перекрытии цервикального канала, мешающего сперматозоидам попасть в матку;
- При иммунологическом бесплодии — у некоторых женщин организм вырабатывает антитела, убивающие сперматозоиды;
- При онкологических или иных заболеваниях у мужчин — противораковые препараты, химиотерапия серьезно снижают репродуктивную функцию мужского организма. В этом случае забор спермы осуществляется до лечения и криоконсервируется (замораживается) для использования в будущем;
- При бесплодии неизвестного происхождения и при отсутствии явных причин безуспешного зачатия.
Также искусственную инсеминацию в клинике “За Рождение” назначают женщинам, не имеющим супруга или постоянного полового партнера, но желающим иметь ребенка. В этом случае они могут воспользоваться спермой анонимного донора, выбрав его в имеющейся у нас картотеке, или обратиться за помощью к знакомому мужчине. В этом случае он должен пройти соответствующее медобследование.
Этап 6 — Поддержание беременности
После проведения экстракорпорального оплодотворения важно контролировать, как проходит развитие эмбриона. Может понадобиться гормональная терапия, которая будет назначена только по результатам ультразвукового исследования и анализов.. Спустя 14 дней после переноса эмбриона в полость матки необходимо сдать анализ на уровень гормона ХГЧ, по результатам которого можно делать вывод о наступлении беременности.
Спустя 14 дней после переноса эмбриона в полость матки необходимо сдать анализ на уровень гормона ХГЧ, по результатам которого можно делать вывод о наступлении беременности.
При положительном результате в первый триметр важно регулярно консультироваться с врачом и сдавать все необходимые анализы, позволяющие контролировать состояние женщины и развитие беременности. Поддерживающая гормональная терапия после проведения ЭКО может длиться около 10–12 недель.
















































Искусственная инсеминация в домашних условиях — это интересный и важный процесс, который требует тщательной подготовки. Женщина должна заранее проконсультироваться с врачом, чтобы убедиться, что у нее нет медицинских противопоказаний. Важно выбрать правильное время для процедуры, основываясь наCycle и мониторинге овуляции. Для выполнения инсеминации необходимо обеспечить стерильность всех инструментов и компонентов. Также стоит ознакомиться с инструкцией к использованию спермы и соблюдать все рекомендации. Поддержка партнера в этот момент тоже важна, так как психологический настрой влияет на итоговый результат.